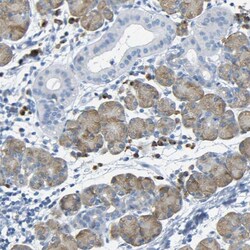

Antibody data
- Antibody Data
- Antigen structure
- References [0]
- Comments [0]
- Validations
- Immunohistochemistry [3]
Submit
Validation data
Reference
Comment
Report error
- Product number
- PA5-53038 - Provider product page

- Provider
- Invitrogen Antibodies
- Product name
- FCRL1 Polyclonal Antibody
- Antibody type
- Polyclonal
- Antigen
- Recombinant protein fragment
- Description
- Immunogen sequence: AMWKEDTGSY WCEAQTMASK VLRSRRSQIN VHRVPVADVS LETQPPGGQV MEGDRLVLIC SVAMGTGDIT FLWYKGAVGL NLQSKTQRSL Highest antigen sequence identity to the following orthologs: Mouse - 47%, Rat - 47%.
- Reactivity
- Human
- Host
- Rabbit
- Isotype
- IgG
- Vial size
- 100 μL
- Concentration
- 0.1 mg/mL
- Storage
- Store at 4°C short term. For long term storage, store at -20°C, avoiding freeze/thaw cycles.
No comments: Submit comment
Supportive validation
- Submitted by
- Invitrogen Antibodies (provider)
- Main image
- Experimental details
- Immunohistochemical staining of FCRL1 in human salivary gland using a FCRL1 Polyclonal Antibody (Product # PA5-53038) shows cytoplasmic positivity in glandular cells and immune cells.
- Submitted by
- Invitrogen Antibodies (provider)
- Main image

- Experimental details
- Immunohistochemical staining of FCRL1 in human lymph node using FCRL1 Polyclonal Antibody (Product # PA5-53038) shows high expression.
- Submitted by
- Invitrogen Antibodies (provider)
- Main image

- Experimental details
- Immunohistochemical staining of FCRL1 in human cerebral cortex using FCRL1 Polyclonal Antibody (Product # PA5-53038) shows low expression as expected.
 Explore
Explore Validate
Validate Learn
Learn Immunohistochemistry
Immunohistochemistry